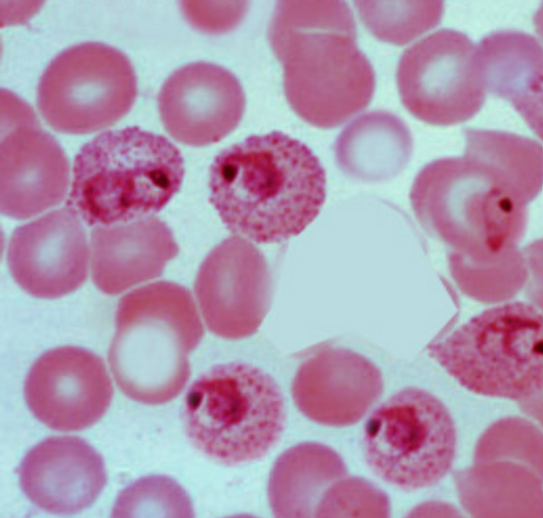

MEGA BOMBS! GMO Parasites Are The mRNA Vector!
Updated: Oct 30, 2022
by Dr. Ariyana Love & Dr. Robert Oldham Young

“The Masters of Evil Terrorize Global Citizens by Spraying Down Cities and Towns with Aerosolized Biosynthetic Artificial Intelligence (Ai) Nanoweapons called Spike Proteins.” – Karen Kingston
Recently, I, Dr. Ariyana Love teamed up with the legendary Dr. Robert O. Young for a mega bombshell reveal about the mRNA vectors in COVID-19 vaccines.


I, Dr. Ariyana Love am a second generation Naturopathic Doctor and a 13-year veteran journalist and researcher. Like me, Dr. Young is a targeted individual.

After providing a proven cure for cancer in 1996, Dr. Young fell under attack by the Luciferian cabal who’s been hell bent on smearing his good name ever since.
I, Dr. Ariyana Love, have been targeted by the Izraeli State since 2017, who’ve been hell bent on smearing my good name with accusations of “racism”.

So we decided to discuss the root cause of disease and address the increase of parasitic infestation Dr. Young has beein seeing all of his clients, from all over the world !

Dr. Young gives chilling evidence of unprecedented parasitic infestations in humans, of which he’s not seen in his entire career. He has stated that parasites are now showing up in 90% of the blood of VAXXed and non-VAXXed individuals alike around the World.


PLEASE WATCH: Part 1 on the Root Cause Of Disease and GMO parasites:

Dr. Robert Young and Dr. Ariyana Love: “The root cause of disease & GMO parasites.” We followed up with a second broadcast for a patent review on the messenger RNA vectors being genetically modified parasites. These GMO parasites are mRNA vectors of deadly synthetic biology that’s being used by Moderna, Pfizer, Novavax, Janssen (J&J), Oxford, and more, to transform the human genome and turn humans into synthetic biology. That’s right, pharmaceutical companies are now using deadly parasites as mRNA vectors for delivering artificial genetic sequences into the human genome through the COVID “VAXXXination”.
PLEASE WATCH: MEGA BOMBS! Deadly GMO Parasites are the mRNA Vectors: Patent Review with Dr. Young & Dr. Love

Since our great reveal on September 28th, Pfizer whistleblower Karen Kingston boldly stepped forward and made an appearance on Stew Peters Show, delivering more bombshell information. She eloquently tied together all aspects of this biological attack against humanity, including the fact that these GMO parasites and mRNA carriers were created with the intention of hooking humans up to AI and “The Internet of Things”. Incidentally, Karen Kingston is also a targeted individual.


Please also review Karen Kingston’s accompanying article to see additional shocking evidence of this biological assault: Part 1: Dismantling the Deceptions of the COVID-19 Story.
The Masters of Evil convinced us that the SARS-CoV-2 mRNA virus produces the highly deadly spiked protein after the mRNA invades cells inside the body. Except there is one major issue with this claim, there is a body of scientific evidence confirming that the mRNA is unstable, fragile, and impotent (weak and useless inside the human body).
According to a March 6, 2021, Chemical and Engineering News article, mRNA lab experiments historically failed because the mRNA invention is so fragile and unstable on its own. This C&EN article states, “Enzymes in the environment and in our bodies are quick to chop mRNA into pieces, making lab experiments difficult and the delivery of mRNA to our cells daunting.” Sanofi’s Chief Technology Officer & Global Head of mRNA Research, Frank DeRosa, had this to say about mRNA, “People use to say that if you looked at it (mRNA) wrong it would fall apart.”

Dr Kathryn Whitehead, head of Chemical and Bioengineering at Carnegie Mellon, expressed her frustration at attempts to conduct mRNA experiments out side of the body and stated, “We don’t even screen (mRNA) in vitro anymore. I find it more informative to test (mRNA) directly inside the animal.”

Per Nature Biotechnology, 2017 peer-reviewed publication, “Overcoming Cellular Barriers for RNA Therapeutics in RNA,” RNA gene-therapies, including mRNA, are unable to infect cells, any cells, due to billions of years of an evolutionary defense mechanism, the lipid bilayer of the human cell membrane.

Patents Within the Patents of ALL VAXXXines!
SEQ ID NO: 1 and SEQ ID NO: 2
There are hundreds of SEQ ID NO’s contained within the COVID VAXXXine serums. We will share with you below our findings on just two ID sequences which do NOT exist in nature!
SEQ ID NO: 1 is patented and owned by the Pirbright Institute which is owned by Bill & Melinda Gates. It contains polypeptides or nucleic acid sequences. These are artificial proteins containing synthetic genetic sequences, in other words it’s synthetic or fake biology. These artificial genetic sequences are Frankensteinian messenger RNA.
SEQ ID No: 1 is “VAXXXINE” Patent #20130216569

The SEQ ID NO: 1 Patent #20130216569 explicitly states that it contains the following deadly protozoan parasite pathogens; Toxoplasma Gondii, Eimeria, Plasmodium, and Theileria Species.

SEQ ID NO: 2 is owned by Boston Biomedical Research Institute and receives significant funding from the NIH, thus Anthony Fauci.
SEQ ID NO: 2 is also synthetic mRNA nucleic acid proteins designed to target and prevent “embryo implantation” in mammals. Humans are classified as mammals.

Embryo implantation is the moment when the fertilized egg is detached from its sheath (zona pellucida), adhered to the endometrium and anchored to it to begin its intrauterine development. Embryo implantation occurs between 5 and 6 days after fertilization. Essentially, SEQ ID NO: 2 aborts embryonic development within the first few days of conception.
SEQ ID NO: 1 can be found within the Pfizer, Moderna, Novavax, Janssen (J&J), Oxford VAXXXines and more, in the COVID jab patents.
SEQ ID NO: 2 is found in Moderna, Pfizer and Novavax VAXXXines and more!
PFIZER VAXXXine
Pfizer Coronavirus VAXXXine Patent #WO2021213945A1 contains both SEQ ID NO: 1 and SEQ ID NO: 2, deadly protozoan parasites that aborts a fertilized egg without ANY Informed Consent from the patient!



Pfizer VAXXX patent:

MODERNA VAXXine
Moderna Sars-cov-2 mRNA Domain VAXXXines Patent #WO2021159040A2 contains SEQ ID NO: 2 birth control parasites without ANY Informed Consent from the patient.

Moderna VAXXX patent #1
Moderna Delivery and Formulation of Engineered Nucleic Acids VAXXXine Patent #US10898574B2 contains SEQ ID NO: 1, with deadly protozoan parasites and without ANY Informed Consent from the patient.

Moderna VAXXX patent #2

NOVAVAXXX VAXXine
Novavax Coronavirus VAXXXine Formulations Patent #US20210228709A1 contains both SEQ ID NO: 1 and SEQ ID NO: 2 thus it contains both birth control and deadly protozoan parasites without the knowledge or ANY Informed Consent from the patient!


Novavax VAXXX patent


JANSSEN (J&J) VAXXXine
Janssen (J&J) Compositions and Methods for Preventing and Treating Coronavirus Infection-SARS-Cov-2 Vaccines Patent #WO2021155323A1 contains SEQ ID NO: 1 with deadly protozoan parasites without the knowledge and ANY Informed Consent from the patient.

Janssen (J&J) VAXX patent

OXFORD VAXXXine
Oxford Compositions and Methods For Inducing An Immune Response VAXXXine Patent #WO2021181100A1 contains SEQ ID NO: 1 with deadly protozoan parasites without the knowledge and ANY Informed Consent from the patient.

Oxford VAXXX patent
PARASITES AS mRNA VECTORS
This BMC study verify’s that deadly parasites were indeed developed as messenger RNA carriers by the World Health Organization, in 2018. The most deadly of the 5 Malaria parasites, Plasmodium Falciparum, Toxoplasma gondii, Trypanosoma cruzi and the Plasmodium spp. in particular, these are all mentioned as mRNA vector exports for vaxxxines in mammal (human) cells.
The following illustration below shows the GMO parasite mRNA vectors in brown squiggly lines with a round head.
You can see there are things attached to the parasites and a coil at the parasites tail to represent the genetic sequence. This graph outlines how the parasites enter the cell membrane through ruptured holes and make their way to the cell nucleus where it delivers the mRNA and genetic changes are made to the cellular DNA.

mRNA parasites – BMC
According to the NIH website:
“Chagas’ disease is caused by the protozoan parasite Trypanosoma cruzi which has been identified in the COVID VAXXXines and may cause potentially life-threatening diseases of the heart and gastrointestinal tract.”
Is the COVID inoculation inducing a parasitic attack on the heart and other vital organs like the liver, placenta and women’s reproduction?

Is “Myocarditis” diagnosis actually CHAGAS?
The 70 percent NOW infected in the Western Hemisphere has increased to over 90 percent infected directly caused by the mRNA Parasite containing VAXXines and the intentional implantation of graphene, ferric oxide and 5 Malaria parasites of Trypanosoma cruzi, Plasmodium falciparum, Toxoplasma gondii and/or the Plasmodium spp. in particular, are all mentioned as mRNA vector exports for VAXXXines in mammal (human) cells!

If the patient is currently asymptomatic, there is a high risk with VAXXination and the implantation of magnetic ferric oxide attached to a base of reduced graphene creating a human quantum linked at 26 mG coming from 4G and 5G pulsating microwave causing radiation poisoning and decompensated acidosis of the interstitial fluids of the Interstitium leading to pathological blood coagulation, oxygen deprivation, hypoxia and lung, heart, kidney, pancreas, spleen, liver, gallbladder, reproductive, thyroid, stomach, bowel and brain dis-eases.

In our opinion it is important to Understand and to Test the Biochemistry of the Interstitium Organ, the Largest Organ of the Human Body and its Interstitial Fluids Which Surround Every Body Cell! The Interstitium Organ Manages Cellular Health, Energy and Metabolic Waste. It is at the Core of Human Health and Fitness or Sickness and Disease! – https://staging.drrobertyoung.com/blog/search/interstitial%20



The VAXXXination of the mRNA VAXXine containing eggs from the Trypanosoma cruzi, Plasmodium falciparum, Toxoplasma gondii and/or the Plasmodium spp. in particular, directly into the interstitial fluids of the Interstitium and the eventual hatching of these eggs at body temperature, may lead to acute or chronic Chagas disease caused by the very MALARIA parasites Dr. Young identified and observed in the Pfizer VAXXXine as seen above.

Symptoms of Chagas or Trypanosoma Disease Include:
1. Fever 2. Headache 3. Body aches 4. Rash 5. Swelling around the eyelids
6. Enlarged heart 7. Heart failure 8. Stroke 9. Life-threatening ventricular arrhythmias 10. Cardiac arrest, and even more life threatening symptomologies listed below . . .

Below is a recent micrograph under pHase Contrast Microscopy of Toxoplasma Malaria and a video by Dr. Robert Oldham Young revealing the birth of many Trypanosoma Cruzi parasites from a human red blood cell in real time of one of his clients.


So What Is Causing the Increases in Excess Deaths and the Inversion From SARS or Severe Acute Respiratory Syndrome to Myocarditis?
Excess deaths in 2020 have inverted from Acute Respiratory Disease to Ischemic Heart Disease & Heart Failure!
Spring 2020:
Acute resp infection – 32%
Diabetes – 22%
Ischemic heart disease -14%
Heart Failure – 7%
Spring 2022:
Acute Respiratory Infection dropped from 32% to 10%
Diabetes increased from 22% to 23%
Ischemic heart disease increased from 14% to 30%
Heart Failure increased from 7% to 31%

The Answer is Simple and Obvious!
The Genetically Modified RNA VAXXXines Containing Cyctotoxic, Genotoxic and Magnetic Toxic Graphene and Ferric Oxide When Linked With Pulsating 4G and/or 5G Microwave Radiation at 2.4 mG to 26 mG from Death Towers or What Scientism Calls the CoVid – 19 Virus Leading to the DEATH BOMB from the VAXXination Containing Deadly Genetic Modified Nucleic Acids or mRNA contained in a Lipid Capsid of Genetically Modified Malaria Parasites Leading to the Cause of Excess Heart, Reproductive and Brain Injuries Including Sudden Death or What is NOW Know as Sudden Death Syndrome or DEATH BY ANY VAXXXINATION!

Related
To learn more about the nondisclosed ingredients in the coronavirus vaxxines read my latest peer-reviewed published article by Acta Scientific Medical Science Journal, ASMS-22-RW-150 entitled “Scanning & Transmission Electron Microscopy Reveals Graphene Oxide in CoV-19 Vaccines”


Watch, listen, learn and then SHARE with EVERYONE YOU LOVE & CARE ABOUT!

Special guest Dr. Robert Young makes his first appearance on the show to speak with Liberty Man about his microscopy and spectroscopy findings in the gene juice injections.

Dr. Young and Liberty Man talk about FDA corruption and share perspectives on the nanotechnology aspects of the shots, including topics such as RNA interference, toxicity, shedding, blood clots, and electromagnetic frequencies, and how all of this plays into the larger agenda of a digital ID social-credit prison system.
Healing At All Costs Dr. Robert Young interview with Johnny Cirucci – Full Interview

Support the work, research and findings of Dr. Robert O. Young at: https://www.givesendgo.com/research

No donation is too small and will be appreciated and used for continuous research, publications and public education!
* * *
As a special thank you for your donation, I will answer one health or lifestyle related question.
After your donation, please email me at: phmiraclelife@gmail.com
Keep your question short and very specific. Please include your first and last name, phone number and email. Your question will be answered within 72 hours.
God bless YOU ALL!
Stay healthy and happy! www.givesendgo.com/researchwww.drrobertyoung.com/blog








For information on how you can detox and fortify your immune system against this biological attack, you can schedule a consultation with Dr. Love, by clicking here!
Please support the research of Dr. Love, by CLICKING HERE!
Please Support the work, research and findings of Dr. Robert O. Young by clicking here: https://www.givesendgo.com/research
Learn The Truth About Viruses, Vaccines and the Viral Theory?






